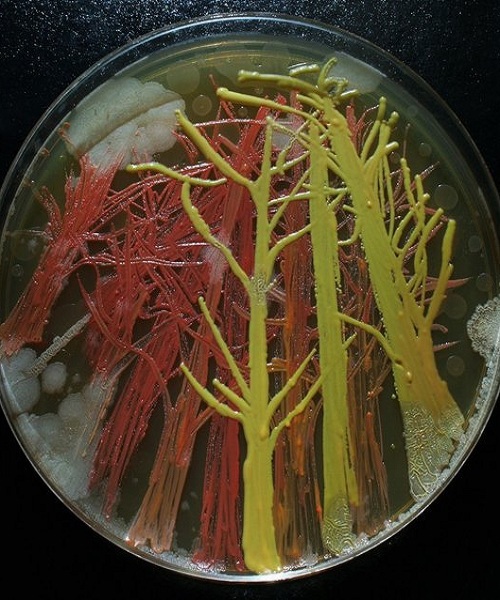

Những bông hoa, rừng cây cổ thụ, đàn sứa biển sinh động từ vi khuẩn bung nở dưới bàn tay sáng tạo của nữ nghệ sĩ người Mỹ.

Nghệ sĩ truyền thông đa phương tiện Maria Peñil Cobo sinh tại Tây Ban Nha và sinh sống ở Massachusetts, Mỹ. Cobo thường lấy cảm hứng từ tự nhiên cho các tác phẩm nghệ thuật của mình.

Thay vì dựa vào phong cảnh đại dương và những cánh rừng hùng vĩ, Cobo tỏ ra thích thú với những hệ sinh thái nhỏ hơn rất nhiều.

Trong 5 năm qua, Cobo dành thời gian nuôi cấy nhiều loài vi khuẩn nhiều màu sắc với sự hỗ trợ của tiến sĩ Mehmet Berkmen, một nhà vi trùng học, và sau đó vẽ vi khuẩn thành những kiệt tác tuyệt đẹp.

"Công việc này rất khó xét về mặt kỹ thuật", Berkmen, nhà khoa học ở công ty New England Biolabs, Massachusetts, Mỹ, cho biết.

"Bạn cần phải hình dung những loài vi khuẩn chúng tôi sử dụng thuộc các loài khác nhau… Mỗi loài phát triển và tiêu hóa khác nhau. Một số tạo nên màu sắc ngay lập tức, trong khi các loại khác già đi và sau đó có màu", Berkmen nói.
Berkmen dạy Cobo cách vẽ bằng vi khuẩn trên thạch trắng, một dạng chất sệt cho phép rừng vi khuẩn sinh trưởng. Nữ nghệ sĩ sử dụng giá vẽ là đĩa dẹt dùng trong phòng thí nghiệm.

Cobo từng thử vẽ bằng vi khuẩn tìm thấy trên môi cô, thu thập bằng cách chạm môi vào đĩa dẹt, cùng với vi khuẩn phát triển khi cô đặt chìa khóa nhà lên đĩa.

Cobo hy vọng tác phẩm của mình sẽ làm thay đổi cách nhìn của công chúng về vi khuẩn từ một nguồn gây sợ hãi đến tổ chức sinh vật thu hút trí tò mò và đáng được đón nhận.

Theo Cobo, vi khuẩn là một phần bình thường trong cuộc sống con người. Chúng sống ở mọi nơi quanh chúng ta và thậm chí bên trong cơ thể người.

"Tôi là một nhà khoa học và tôi đánh giá cao dự án này. Khi chúng ta làm khoa học, luôn có yếu tố nghệ thuật, và khi Cobo sáng tạo nghệ thuật thuần túy, yếu tố khoa học nằm trong những gì chúng ta đang quan sát. Chúng ta đang quan sát những hiện tượng khoa học", Berkmen chia sẻ.
Theo VnExpress
Mời bạn xem thêm:
Chàng trai vẽ tranh màu nước đẹp đến từng chi tiết
Chàng trai vẽ tranh từ trí nhớ chi tiết đến khó tin
Cô gái vẽ tranh màu nước đẹp đến từng chi tiết
